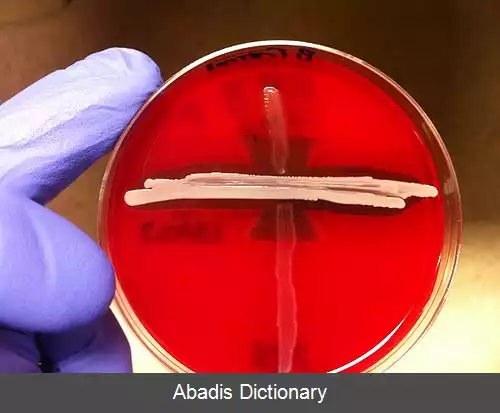
عکس استرپتوکوک آگالاکتیه

استرپتوکوک آگالاکتیه. استرپتوکوک آگالاکتیه ( Streptococcus agalactiae ) یا استرپتوکوک های گروه B، گونه ای بتا همولیتیک از استرپتوکوک است. [ ۱]
استرپتوکوک آگالاکتیه به شکل دیپلوکوک ( جفت کوکسی ) گرم مثبت در زیر میکروسکوپ دیده می شود. این باکتری کاتالاز منفی و غیر متحرک است. استرپتوکوک آگالاکتیه به شکل جفت یا زنجیره های کوتاه دیده می شود. [ ۲]
از تست های CAMP و هیدرولیز هیپورات سدیم برای تشخیص استرپتوکوک گالاکتیه استفاده می شود. هر دو تست در مورد این باکتری، مثبت است. این باکتری به صفرا حساس است و در حضور آن، لیز می شود. کپسول پلی ساکاریدی و ضد فاگوسیتی استرپتوکوک آگالاکتیه مهمترین فاکتور بیماریزایی است. [ ۳]
استرپتوکوک آگالاکتیه بر اساس آنتی سرم های واکنش دهنده با کپسول پلی ساکاریدی، به ۹ سروتیپ تقسیم بندی می شود. فقط سروتیپ های Ia و Ib و II و III و V مرتبط با عفونت های مهاجم انسانی می باشند. [ ۴]
این باکتری، فلور نرمال روده در برخی انسان ها است و می تواند جایگاه های ثانویه مانند واژن را در زنان ( ۱۰٪ تا ۳۰٪ ) کلونیزه کند. در هنگام تولد و عبور نوزاد از کانال زایمان، نوزاد می تواند آلوده شود. عفونت در نوزادان به شکل مننژیت، پنومونی و سپتی سمی ( عفونت خون ) خود را نشان می دهد. اگر عفونت قبل از اتمام هفته اول ( روزهای ۰ تا ۷ ) در نوزاد ایجاد شود، به آن هجوم اولیه ( Early - onset ) می گویند که به صورت سپتی سمی مایل به پنومونی تظاهر می یابد. اگر عفونت پس از اتمام هفته اول ( روزهای ۷ تا ۹۰ ) در نوزاد ایجاد شود، به آن هجوم تأخیری ( late - onset ) می گویند که به صورت سپتی سمی مایل به مننژیت تظاهر می یابد. علائم مننژیت در کودکان شبیه مننژیت بالغین نیست مانند عدم وجود سفتی گردن و وجود نشانه های غیر اختصاصی مانند تب و استفراغ که پیامد آن، تشخیص دیرتر بیماری خواهد بود. [ ۱]
درمان پیشگیرانه با آنتی بیوتیک ها مانند پنی سیلین در هنگام تولد بچه، احتمال عفونت را کاهش می دهد. هنوز پژوهش ها در مورد ساخت واکسن استرپتوکوک آگالاکتیه ادامه دارد. [ ۱]
این باکتری در بسیاری از پستانداران مانند شتر، سگ، گربه، دولفین، فک و حتی خزندگان و ماهی ها دیده شده است. این باکتری در گاو ایجاد ماستیت ( ورم پستان ) می کند که به شکل های تب زای حاد و مزمن تحت حاد دیده می شود. این امر موجب کاهش تولید شیر در گاو می شود ( آگالاکتیه در لغت به معنای بدون شیر است ) . از این رو در صنعت دامپروری اهمیت ویژه ای دارد. [ ۵]
این نوشته برگرفته از سایت ویکی پدیا می باشد، اگر نادرست یا توهین آمیز است، لطفا گزارش دهید: گزارش تخلفاسترپتوکوک آگالاکتیه به شکل دیپلوکوک ( جفت کوکسی ) گرم مثبت در زیر میکروسکوپ دیده می شود. این باکتری کاتالاز منفی و غیر متحرک است. استرپتوکوک آگالاکتیه به شکل جفت یا زنجیره های کوتاه دیده می شود. [ ۲]
از تست های CAMP و هیدرولیز هیپورات سدیم برای تشخیص استرپتوکوک گالاکتیه استفاده می شود. هر دو تست در مورد این باکتری، مثبت است. این باکتری به صفرا حساس است و در حضور آن، لیز می شود. کپسول پلی ساکاریدی و ضد فاگوسیتی استرپتوکوک آگالاکتیه مهمترین فاکتور بیماریزایی است. [ ۳]
استرپتوکوک آگالاکتیه بر اساس آنتی سرم های واکنش دهنده با کپسول پلی ساکاریدی، به ۹ سروتیپ تقسیم بندی می شود. فقط سروتیپ های Ia و Ib و II و III و V مرتبط با عفونت های مهاجم انسانی می باشند. [ ۴]
این باکتری، فلور نرمال روده در برخی انسان ها است و می تواند جایگاه های ثانویه مانند واژن را در زنان ( ۱۰٪ تا ۳۰٪ ) کلونیزه کند. در هنگام تولد و عبور نوزاد از کانال زایمان، نوزاد می تواند آلوده شود. عفونت در نوزادان به شکل مننژیت، پنومونی و سپتی سمی ( عفونت خون ) خود را نشان می دهد. اگر عفونت قبل از اتمام هفته اول ( روزهای ۰ تا ۷ ) در نوزاد ایجاد شود، به آن هجوم اولیه ( Early - onset ) می گویند که به صورت سپتی سمی مایل به پنومونی تظاهر می یابد. اگر عفونت پس از اتمام هفته اول ( روزهای ۷ تا ۹۰ ) در نوزاد ایجاد شود، به آن هجوم تأخیری ( late - onset ) می گویند که به صورت سپتی سمی مایل به مننژیت تظاهر می یابد. علائم مننژیت در کودکان شبیه مننژیت بالغین نیست مانند عدم وجود سفتی گردن و وجود نشانه های غیر اختصاصی مانند تب و استفراغ که پیامد آن، تشخیص دیرتر بیماری خواهد بود. [ ۱]
درمان پیشگیرانه با آنتی بیوتیک ها مانند پنی سیلین در هنگام تولد بچه، احتمال عفونت را کاهش می دهد. هنوز پژوهش ها در مورد ساخت واکسن استرپتوکوک آگالاکتیه ادامه دارد. [ ۱]
این باکتری در بسیاری از پستانداران مانند شتر، سگ، گربه، دولفین، فک و حتی خزندگان و ماهی ها دیده شده است. این باکتری در گاو ایجاد ماستیت ( ورم پستان ) می کند که به شکل های تب زای حاد و مزمن تحت حاد دیده می شود. این امر موجب کاهش تولید شیر در گاو می شود ( آگالاکتیه در لغت به معنای بدون شیر است ) . از این رو در صنعت دامپروری اهمیت ویژه ای دارد. [ ۵]
wiki: استرپتوکوک آگالاکتیه
